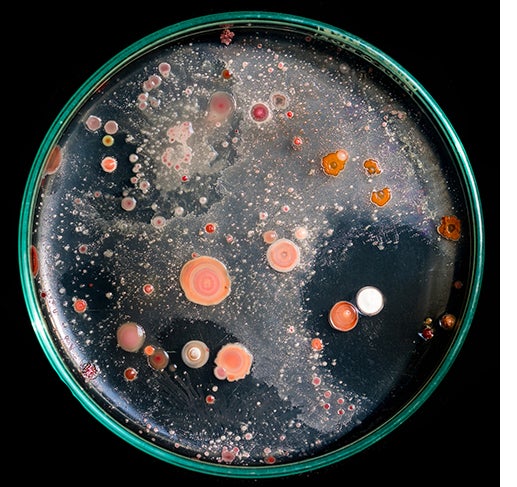
soil bacteria

The National Science Foundation has announced a $22 million grant to establish a “BioFoundry” laboratory for the study of extreme microorganisms with collaborating facilities at UC Riverside, UC Santa Barbara, and Cal Poly Pomona.
The BioFoundry for Extreme and Exceptional Fungi, Archaea, and Bacteria, or ExFAB, will focus on developing techniques to learn from nature’s more unusual microorganisms. These microbes are considered “extreme” because they have unusual nutritional requirements, grow at extremely high or low temperatures, or grow without oxygen—traits that make them difficult to study with existing laboratory equipment.
Researchers at the three institutions hope to harness their outlier characteristics for applications ranging from the biosynthesis of fuels and other products to the bioremediation of polluted water and soil. The ExFAB laboratory also will advance scientific knowledge about the “rules of life” by revealing how these organisms can thrive in some of Earth’s most extreme environments.
UCR's Ian Wheeldon, a chemical and environmental engineering professor in UCR’s Marlan and Rosemary Bourns College of Engineering and Jason Stajich, a professor and vice chair of Department of Microbiology and Plant Pathology at UCR's College of Natural and Agricultural Sciences, are co-principal Investigators for the grant project.
“ExFAB provides an exciting opportunity to open synthetic biology to the vast diversity of microbes that nature provides,” said Wheeldon, an expert in synthetic biology and engineering non-conventional microbes.
“The current focus of synthetic biology has been to develop new approaches to engineering a small number of commonly used microbes,” Wheeldon said. “This facility will dramatically broaden this approach by enabling synthetic biology in any microbe.”
The UCR facility is expected to begin operations early next year. It will be in Bourns Hall on UCR’s main campus, cover about 1,500 square feet, and have four employees, Wheeldon said.
Research bottlenecks at the new facility will be eliminated using automated liquid handlers, novel robotic workflows, technology powered by machine learning, and first-of-its-kind instrumentation, Wheeldon said. For example, a researcher who needs to know how a hundred microbial species grow in 10 different environmental conditions would no longer have to do 1,000 different painstaking experiments because of the automated processes in the ExFAB.
In just one example, laboratory is expected to advance research by UCR associate professor Yujie Men, who has identified bacteria species that can destroy certain “forever chemical” water pollutants, which have stubbornly strong carbon-to-fluorine bonds that allow them to persist for decades in the environment. Such bacteria are needed for the economical clean-ups of polluted groundwater resources used by drinking water providers throughout the nation.
“This leading-edge intersection of technology and the life sciences is tremendously important,” said Christoper S. Lynch, dean of the Bourns College of Engineering. “It opens new opportunities for discoveries and breakthroughs and provides new facilities for sophisticated experimental work. This collaboration with UC Santa Barbara and Cal Poly Pomona will help each of our respective university systems to share resources, expand our research footprints, and strengthen the impacts of our breakthroughs and innovations.”
ExFAB will also establish educational programs to attract and train the future biotechnology workforce from the UC and Cal State systems, including a 10-week research internship program for Cal State master’s students at UCSB or UCR. ExFAB will also offer summer training for researcher who will use the laboratory.
“We are extremely excited because this funding enables us to build infrastructure that nobody, especially in academia, has had access to before,” said Michelle O’Malley, a professor of chemical engineering and bioengineering at UCSB and an ExFAB co-director.”